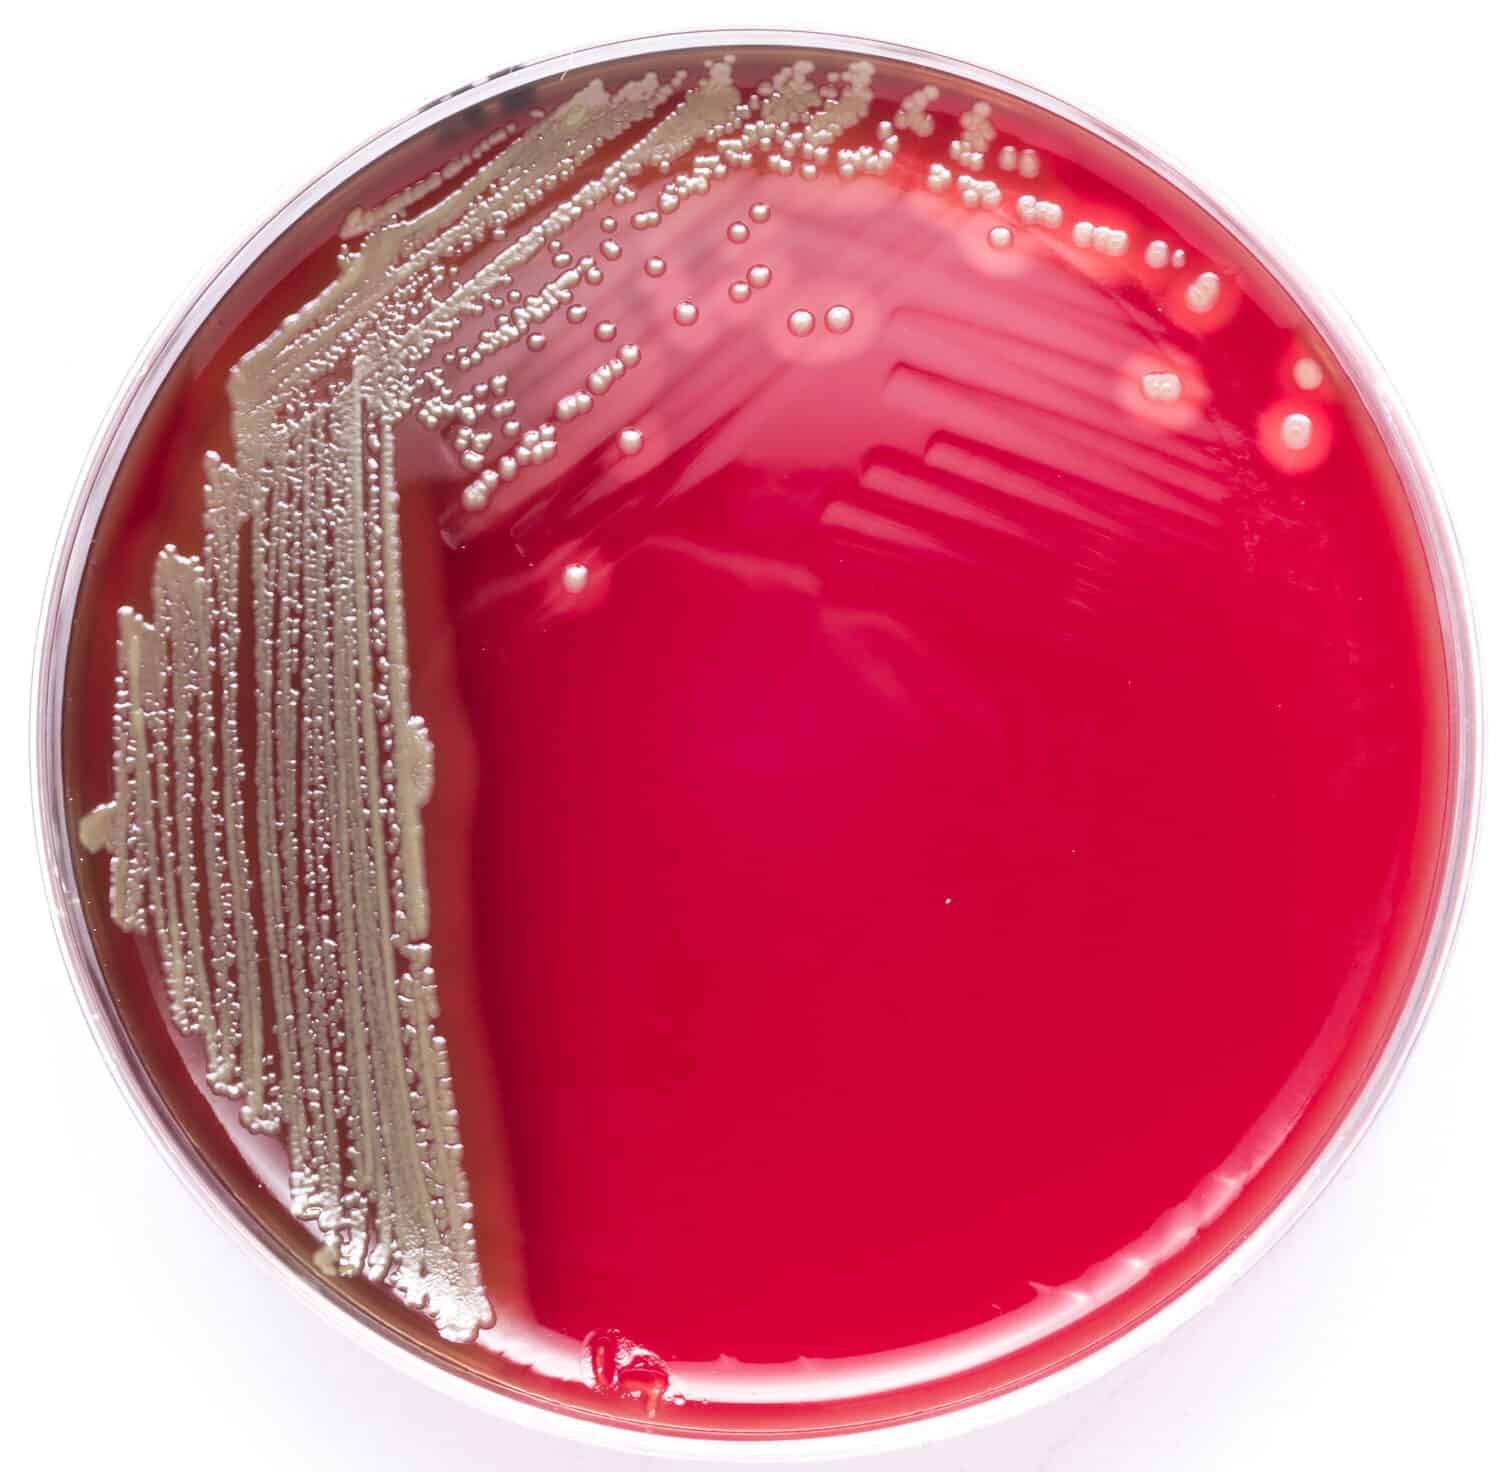

[1] J. Hanson, S. Smith, J. Stewart, P. Horne, and N. Ramsamy, “Melioidosis-a illness of socioeconomic drawback,” PLoS Negl. Trop. Dis., vol. 15, no. 6, p. e0009544, 2021.
[2] Facilities for Illness Management and Prevention (CDC), “Indicators and signs,” CDC, 22-Nov-2021. [Online]. Obtainable: https://www.cdc.gov/melioidosis/signs/index.html
[3] W. J. Wiersinga et al., “Melioidosis,” Nat. Rev. Dis. Primers, vol. 4, no. 1, p. 17107, 2018.
[4] N. Luangasanatip et al., “The worldwide impression and cost-effectiveness of a melioidosis vaccine,” BMC Med., vol. 17, no. 1, p. 129, 2019.
[5] R. Perumal Samy, B. G. Stiles, G. Sethi, and L. H. Ok. Lim, “Melioidosis: Medical impression and public well being menace within the tropics,” PLoS Negl. Trop. Dis., vol. 11, no. 5, p. e0004738, 2017.
[6] A. C. Cheng and B. J. Currie, “Melioidosis: epidemiology, pathophysiology, and administration,” Clin. Microbiol. Rev., vol. 18, no. 2, pp. 383–416, 2005.
[7] J. H. Fong, N. Pillai, C. G. Yap, and N. Ok. Jahan, “Incidences, case fatality charges and epidemiology of melioidosis worldwide: A overview paper,” OAlib, vol. 08, no. 06, pp. 1–20, 2021.
[8] D. Limmathurotsakul et al., “Rising incidence of human melioidosis in Northeast Thailand,” Am. J. Trop. Med. Hyg., vol. 82, no. 6, pp. 1113–1117, 2010.
[9] Facilities for Illness Management and Prevention (CDC), “Transmission,” CDC, 30-Jun-2021. [Online]. Obtainable: https://www.cdc.gov/melioidosis/transmission/index.html
[10] M. Jayaram, “Melioidosis · ought to or not it’s a notifiable illness in Malaysia?,” E-mjm.org, 2005. [Online]. Obtainable: https://e-mjm.org/2005/v60n5/Melioidosis.pdf. [Accessed: 06-Jul-2023].
[11] Facilities for Illness Management and Prevention (CDC), “Therapy,” CDC, 30-Jun-2021. [Online]. Obtainable: https://www.cdc.gov/melioidosis/remedy/index.html
[12] Facilities for Illness Management and Prevention (CDC), “Prevention,” CDC, 03-Mar-2020. [Online]. Obtainable: https://www.cdc.gov/melioidosis/prevention/index.html